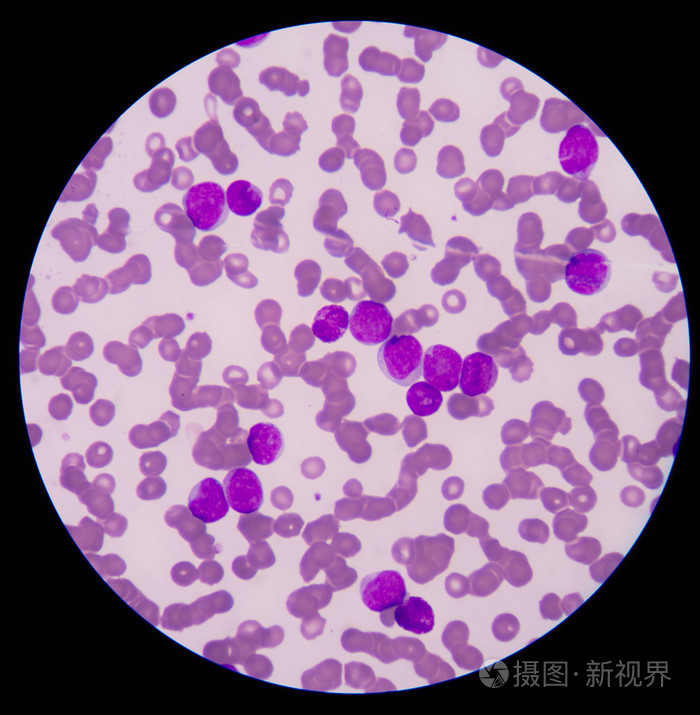
涂片显示大量的癌症白血病 cel

癌细胞x白血球

【工作细胞】癌细胞x白细胞:错的是你还是世界?
图片尺寸1330x831
癌细胞x白血球
图片尺寸640x1280
活动作品如果把台词换一下白细胞和癌细胞阿珍爱上了阿强
图片尺寸1128x705
癌细胞,白细胞,美,水平画幅,抗体
图片尺寸1200x900
工作细胞第7集癌细胞帅气登场癌白cp诞生这对cp你站吗
图片尺寸650x414
癌细胞x白血球
图片尺寸640x1280![[工作细胞癌白]癌白](https://imgs.wantubizhi.com/img/735A5D1F980B52A636CC46F12F2D1A73B7CB9AE6BE5E7D68B8ED2CBE31A5CF77EE5815199918E7E056253D556F522405D3F56A7B36D8B9BD03B5AFF5F3713C0DAF9821A8955608DC2ABBF13E0BD868115AC9033C8B56476CE48263332ECCCDD7)
[工作细胞癌白]癌白
图片尺寸1890x1181
丁香园论坛 - 专业医生社区,医学,药学,生命科学,科研学术交流
图片尺寸2560x1920
涂片显示大量的癌症白血病 cel
图片尺寸700x715
同样的白细胞危急值,同样的淋巴细胞比例升高,看似相同,实则不然_腾讯
图片尺寸662x655
工作细胞第7集:癌细胞帅气登场,癌白cp诞生,这对cp你站吗?_白血球
图片尺寸880x555
癌细胞大杀四方,白细胞被围困,2白毛同框好可爱,奇怪cp增加了
图片尺寸640x358
【癌白】【癌细胞x白细胞】工作细胞——邪教cp搞起来
图片尺寸1019x637
癌白
图片尺寸1600x1200
工作细胞癌细胞帅气登场癌白cp诞生这对cp你站吗
图片尺寸1280x720
工作细胞-癌细胞
图片尺寸400x290
2,播放超七千万!这部反差萌的科普动画凭什么这么火?_癌细胞
图片尺寸1080x607
changes in subfoveal choroidal thickness during preg
图片尺寸2089x1575
然而,白血球直到癌细胞出现在他面前,他才发现刚才的那位细胞,原来是
图片尺寸660x423
persisting right-sided chylothorax in a patient with chronic
图片尺寸785x1182





![[工作细胞癌白]癌白](https://imgs.wantubizhi.com/img/735A5D1F980B52A636CC46F12F2D1A73B7CB9AE6BE5E7D68B8ED2CBE31A5CF77EE5815199918E7E056253D556F522405D3F56A7B36D8B9BD03B5AFF5F3713C0DAF9821A8955608DC2ABBF13E0BD868115AC9033C8B56476CE48263332ECCCDD7)


















![[工作细胞癌白]癌白](https://i2.hdslb.com/bfs/archive/006afaf34030f9a763a520e87baa61fe2365f756.jpg)